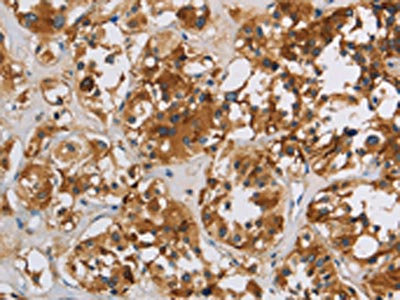

IGF2R Antibody
-
中文名稱:IGF2R兔多克隆抗體
-
貨號:CSB-PA632749
-
規格:¥1100
-
圖片:
-
The image on the left is immunohistochemistry of paraffin-embedded Human liver cancer tissue using CSB-PA632749(IGF2R Antibody) at dilution 1/50, on the right is treated with synthetic peptide. (Original magnification: ×200)
-
The image on the left is immunohistochemistry of paraffin-embedded Human thyroid cancer tissue using CSB-PA632749(IGF2R Antibody) at dilution 1/50, on the right is treated with synthetic peptide. (Original magnification: ×200)
-
Gel: 6%SDS-PAGE, Lysate: 40 μg, Lane: Jurkat cells, Primary antibody: CSB-PA632749(IGF2R Antibody) at dilution 1/400, Secondary antibody: Goat anti rabbit IgG at 1/8000 dilution, Exposure time: 3 minutes
-
-
其他:
產品詳情
-
Uniprot No.:
-
基因名:
-
別名:300 kDa mannose 6 phosphate receptor antibody; 300 kDa mannose 6-phosphate receptor antibody; Cation independent mannose 6 phosphate receptor antibody; Cation-independent mannose-6-phosphate receptor antibody; CD222 antibody; CD222 antigen antibody; CI Man 6 P receptor antibody; CI Man-6-P receptor antibody; CI MPR antibody; CI-M6PR antibody; CI-MPR antibody; CIMPR antibody; IGF 2 receptor antibody; IGF 2R antibody; IGF II receptor antibody; IGF-II receptor antibody; IGF2 receptor antibody; Igf2r antibody; Insulin like growth factor 2 receptor antibody; Insulin like growth factor II receptor antibody; Insulin-like growth factor 2 receptor antibody; Insulin-like growth factor II receptor antibody; M6P R antibody; M6P/IGF2 receptor antibody; M6P/IGF2R antibody; M6PR antibody; mannose 6 phosphate receptor antibody; mannose 6 phosphate receptor, cation independent antibody; MPR 300 antibody; MPR300 antibody; MPRI antibody; MPRI_HUMAN antibody
-
宿主:Rabbit
-
反應種屬:Human,Mouse
-
免疫原:Synthetic peptide of Human IGF2R
-
免疫原種屬:Homo sapiens (Human)
-
標記方式:Non-conjugated
-
抗體亞型:IgG
-
純化方式:Antigen affinity purification
-
濃度:It differs from different batches. Please contact us to confirm it.
-
保存緩沖液:-20°C, pH7.4 PBS, 0.05% NaN3, 40% Glycerol
-
產品提供形式:Liquid
-
應用范圍:ELISA,WB,IHC
-
推薦稀釋比:
Application Recommended Dilution ELISA 1:1000-1:2000 WB 1:200-1:1000 IHC 1:50-1:200 -
Protocols:
-
儲存條件:Upon receipt, store at -20°C or -80°C. Avoid repeated freeze.
-
貨期:Basically, we can dispatch the products out in 1-3 working days after receiving your orders. Delivery time maybe differs from different purchasing way or location, please kindly consult your local distributors for specific delivery time.
-
用途:For Research Use Only. Not for use in diagnostic or therapeutic procedures.
相關產品
靶點詳情
-
功能:Mediates the transport of phosphorylated lysosomal enzymes from the Golgi complex and the cell surface to lysosomes. Lysosomal enzymes bearing phosphomannosyl residues bind specifically to mannose-6-phosphate receptors in the Golgi apparatus and the resulting receptor-ligand complex is transported to an acidic prelysosomal compartment where the low pH mediates the dissociation of the complex. The receptor is then recycled back to the Golgi for another round of trafficking through its binding to the retromer. This receptor also binds IGF2. Acts as a positive regulator of T-cell coactivation by binding DPP4.
-
基因功能參考文獻:
- M. tuberculosis-initiated human mannose receptor signaling regulates macrophage recognition and vesicle trafficking by gamma Fc receptors, Grb2, and SHP-1. PMID: 28978467
- IGF2R deletion is associated with motor speech disorders, and language delays. PMID: 28767196
- Heterodimers of the SNX-BAR proteins, SNX1, SNX2, SNX5, and SNX6, are the cargo-selective elements that mediate the retrograde transport of CI-MPR from endosomes to the trans-Golgi networ independently of the core retromer trimer. PMID: 28935632
- Sequence-dependent cargo recognition by SNX-BARs mediates retromer-independent transport of CI-MPR. PMID: 28935633
- Findings indicate that IGF2R expression is controlled posttranscriptionally by two factors that associate with Igf2r mRNA and suggest that miR-195 and CUGBP1 dampen IGF signaling by inhibiting IGF2R translation. PMID: 28716948
- Data show one single nucleotide polymorphism (SNP) in Fox transcription factor FOXO3 (FOXO3) was significantly associated with longevity, and the six SNPs in proto-oncogene protein AKT1 (AKT1) gene and in IGF-2 Receptor (IGF-2R) gene are not. PMID: 26683100
- CREB plays an important role in the inhibition of IGF2R expression by binding to the IGF2R promoter and further suppresses H9c2 cardiomyoblast cell apoptosis induced by IGF2R signaling under hypoxic conditions. PMID: 26610485
- This study showed that Plasma IGF2R levels were positively correlated with plasma HIV viral load. PMID: 25890304
- IGF2R gene polymorphism and circulating IGF2R are associated with T2DM PMID: 25922844
- The macrophage-specific markers CD163, soluble CD163, and soluble MR are increased in septic patients. PMID: 24637679
- Results show that insulin-like growth factor II (IGF-II) overexpression enhanced the levels of amyloid precursor protein (APP) in SK-N-AS neuroblastoma cells. PMID: 25939386
- IGF2R silencing significantly enhanced the chemo-resistance of NSCLC cell lines to cisplatin treatment. PMID: 25402559
- Report genes involved in trafficking of the mannose 6-phosphate receptors between the trans-Golgi network, endosomes and the plasma membrane. PMID: 25278553
- CD222 specifically controls the balance between active and inactive Lck in resting T cells, which guarantees operative T cell effector functions. PMID: 25127865
- Synergistic interactions were detected between SNPs, including a non-synonymous SNP, and diplotypes within IGF2R and ADAMTS19 which may contribute to POF. PMID: 24014609
- AGE-RAGE-induced oxidative stress stimulates the release of endothelial cell DPP-4, which could in turn act on ECs directly via the interaction with M6P/IGF-IIR, further potentiating the deleterious effects of AGEs. PMID: 23984879
- The ubiquitin ligase RNF126 has a role in the retrograde sorting of the CI-MPR. PMID: 24275455
- these data suggest that M6P/IGF-IIR silencing alone is insufficient to confer a tumorigenic phenotype, but can enhance tumorigenicity in an already transformed cell. PMID: 23686499
- Results showed that insulin-like growth factor 2 ApaI and IFG2R Gly1619Arg gene polymorphisms are not associated with male infertility. PMID: 23539881
- The mannose 6-phosphate-binding sites of M6P/IGF2R determine its capacity to suppress matrix invasion by squamous cell carcinoma cells. PMID: 23347038
- Data indicate that the levels of IGF-2R and IGFBP-2 in hepatocellular carcinoma (HCC) tissues were higher than those in adjacent tissues. PMID: 23071652
- The 5-phosphatase OCRL mediates retrograde transport of the mannose 6-phosphate receptor by regulating a Rac1-cofilin signalling module. PMID: 22907655
- demonstrate that functional mannose 6-phosphate(M6P)-binding sites are important for the anti-invasive properties of M6P/IGF2R PMID: 22521359
- M6P/IGF2R truncation mutants may contribute to the cancer phenotype by decreasing the availability of full-length M6P/IGF2Rs to perform tumor-suppressive functions such as binding/internalization of receptor ligands PMID: 22681933
- Serum IGF-2R levels were significantly higher in heart failure patients than in non-failing controls. After heart transplantation, serum IGF-2R levels increased, peaked at the first month, and decreased to near pre-transplantation levels at 6 months. PMID: 21895964
- M6P-IGF2R appears to control plasminogen activation within cells that might be important to restrict plasmin activity to specific sites and substrates. PMID: 22613725
- SNP at 8q24 makes diabetes a risk factor of colorectal cancer via IGF2R, especially in genetically non-risk allele cases. PMID: 22486879
- No evidence that the IGF2R Gly1619Arg variation is associated with recurrent spontaneous abortions. PMID: 21627551
- Data suggest that soluble CREG protein can exert its biological function via glycosylation-independent binding to the extracellular domains 11-13 of cell surface M6P/IGF2R, modulating SMC phenotypic switching from contractile to proliferative. PMID: 21195083
- Leu(27)IGF2 promoted mitogenesis and survival only in explants with intact IGF2R expression. PMID: 20980691
- M6P/IGF2R may be involved in HBV-associated hepatocarcinogenesis by the regulation of its expression level. PMID: 12736721
- Imprinting of IGF2R gene in human is polymorphic, with a minority of individuals showing exclusive expression from the maternal allele. PMID: 8267611
- IGF-2R gene polymorphisms are associated with the susceptibility and pathological development of hepatocellular carcinoma. PMID: 20119675
- IGFIIR/M6PR is nutritionally regulated independently of IGF-II. PMID: 20110184
- Importance of widening the epigenetic investigation of growth restriction to include multiple imprinted loci and highlights potential involvement of the IGF2R locus. PMID: 20104244
- The 1.4 A resolution crystal structure of domain 11 was solved using the anomalous scattering signal of sulfur. It consists of two crossed beta-sheets forming a flattened beta-barrel with a putative IGF-II binding site is at one end. PMID: 11867533
- cDNA probes were used to analyze the gene expression of IGF type 2 receptor in luteinized granulosa cells from different-sized follicles after ovarian hyperstimulation. PMID: 12005306
- blocks apoptosis induced by herpes simplex virus 1 mutants lacking glycoprotein D and is likely the target of antiapoptotic activity of the glycoprotein. PMID: 12021353
- Results suggest that M6P/IGF2R functions as a growth suppressor and its loss or mutation may contribute to development and progression of cancer. PMID: 12149131
- Results suggest that a defect in a post-transcriptional process may exist during synthesis of the M6P/IGF2R in breast cancer cells, leading to failure to express sufficient functional M6P/IGF2R and resulting in the hypersecretion of procathepsin D. PMID: 12165733
- 1,25(OH)(2)D(3) treatment of Caco-2 cells results in activation of latent TGF-beta 1 facilitated by the enhanced expression of IGF-II receptor PMID: 12223346
- findings are consistent with the hypothesis that the insulin-like growth factor-II/mannose 6-phosphate receptor suppresses tumor growth PMID: 12399424
- data suggest that the insulin-like growth factor-II- and Mannose-6-Phosphate-binding functions of the insulin-like growth factor 2 receptor have opposing activities, with respect to growth of prostate cancer cells PMID: 12586773
- the interaction between uPAR and Man-6-P/IGF2R is a low percentage binding event and that suPAR and full-length uPAR bind the Man-6-P/IGF2R by different mechanisms. PMID: 12665524
- defect in USF function may contribute to down-regulation of IGF2R expression in cancer cells. PMID: 12857727
- neutralization of serum IGF-II by sCIMPR plays a major role in IL-6-type cytokine-dependent cell proliferation. PMID: 12959977
- The insulin-like growth factor receptor (IGF-IR) disruption may constitute an effective tool for the control of neovascularization PMID: 14710346
- Review delineates what is currently known about IGF-II/M6P receptor structure, its ligand binding properties and role in lysosomal enzyme transport. It also summarizes the recent data regarding the role of the receptor in the central nervous system. PMID: 15003389
- Nay play a direct role in tumour suppression or an indirect role as a transporter for ligands designated for degradation in the lysosomes. (review) PMID: 15156403
- Increased frequency of the cation dependent-MPR C-allele in patients with major depression, but no involvement in Alzheimer disease noted. PMID: 15167696
顯示更多
收起更多
-
亞細胞定位:Golgi apparatus membrane; Single-pass type I membrane protein. Endosome membrane; Single-pass type I membrane protein.
-
蛋白家族:MRL1/IGF2R family
-
數據庫鏈接:
Most popular with customers
-
-
YWHAB Recombinant Monoclonal Antibody
Applications: ELISA, WB, IHC, IF, FC
Species Reactivity: Human, Mouse, Rat
-
Phospho-YAP1 (S127) Recombinant Monoclonal Antibody
Applications: ELISA, WB, IHC
Species Reactivity: Human
-
-
-
-
-